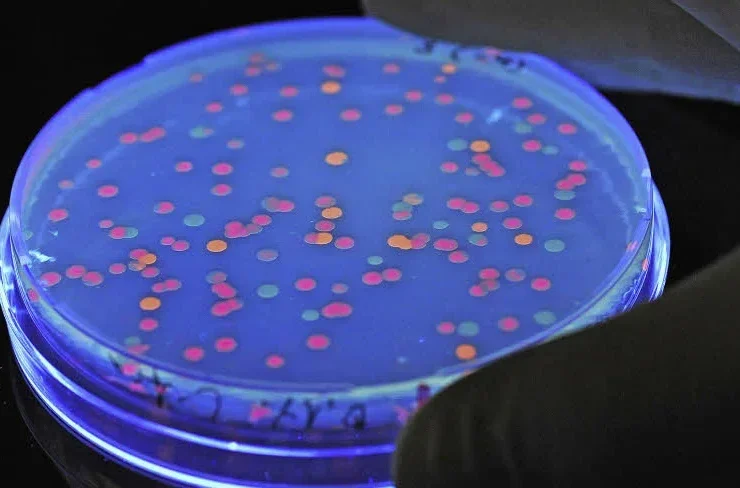

Reisebakterier: Finn ut hvordan de påvirker helsen din på reise. ...
Få rask lindring av reisediaré med Imodium Akut. Lær hvordan du unngår ubehag på reisen. ...
Løs mageproblemer effektivt med reisetabletter. Finn beste valg for deg. ...
Få rask hjelp mot reisediaré. Lær hvordan du kan forebygge og behandle den effektivt. Nyt ferien uten ubehag. ...